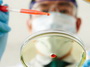
3,5

На борьбу с коронавирусом в Казахстане выделено около 3,5 миллиарда тенге. Такие данные привел первый заместитель премьер-министра - министр финансов Алихан Смаилов, передает корреспондент Tengrinews.kz.
"Средства выделены из правительственного резерва на закуп необходимых медикаментов, а также масок, тепловизоров и другого оборудования, чтобы проводить работу по борьбе с распространением коронавируса.
Это по линии Министерства здравоохранения. Выделено было порядка 3,5 миллиарда тенге. Контролировать (целевое распределение средств. - Прим.) будет Минздрав", - сказал Смаилов, отвечая на вопросы журналистов в Мажилисе.
Отвечая на вопрос о том, что ранее сообщалось о сумме в 1,5 миллиарда тенге на борьбу с коронавирусом, вице-премьер уточнил, что правительством планируются дополнительные расходы, связанные с вывозом казахстанцев из Китая.
30 января сообщалось, что на защиту от коронавируса в Казахстане выделили 1,5 миллиарда тенге.
Комментарии:
Нет комментариев. Почему бы Вам не оставить свой?
Для того чтобы оставить комментарий зарегистрируйтесь и войдите на сайт под своим именем.
Если Вы уже регистрировались то просто войдите на сайт под своим именем.